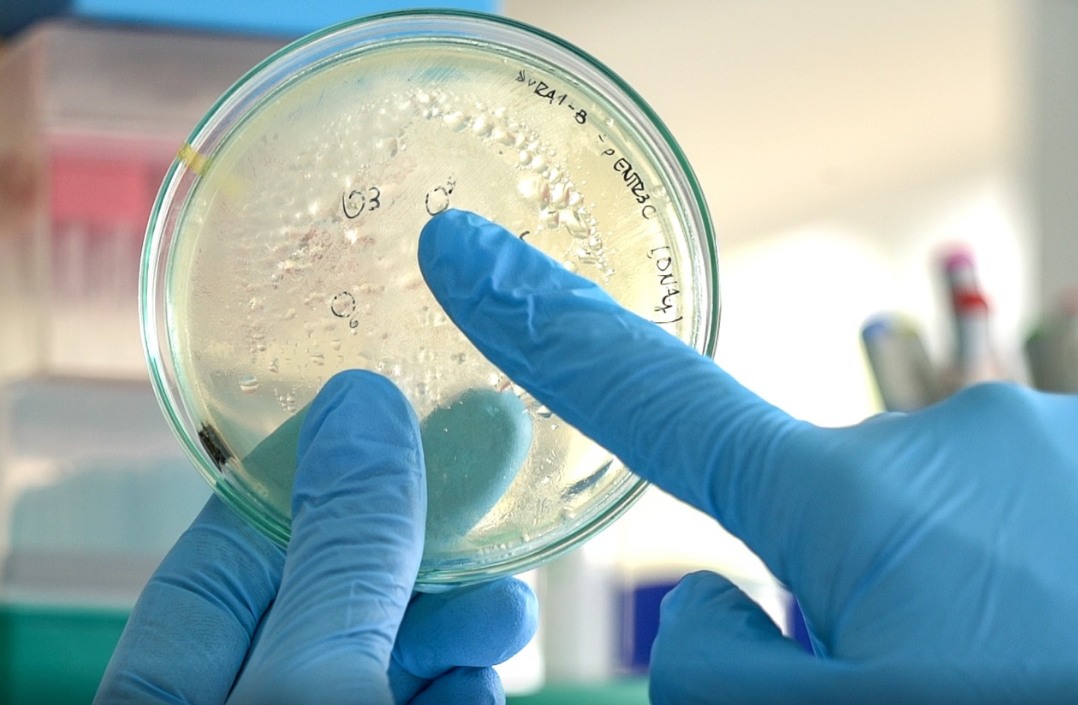
Dos nuevas empresas de alta tecnología nacen de la UNL | Noticias

Dos nuevas empresas nacen a partir de tecnologías desarrolladas por investigadores de la Universidad Nacional del Litoral (UNL) y el Consejo Nacional de Investigaciones Científicas y Tecnológicas (Conicet).
Se trata de Infira SA que propone avanzar con el grado de maduración de un método de mejoramiento vegetal que tiene el potencial de convertir a las plantas en más productivas, resistentes al estrés y resilientes; y Biosynáptica SA que busca el desarrollo de fármacos para el tratamiento de enfermedades neurodegenerativas, como el Parkinson o el Alzheimer, mejorando significativamente la calidad de vida de los pacientes.
La creación de empresas a partir de desarrollos tecnológicos realizados en los laboratorios no es una de las actividades más habituales, sin embargo es una práctica que viene sucediendo hace años en todas las universidades e institutos de investigación del mundo y cuenta con cada vez más herramientas e instrumentos de apoyo.
En el ámbito académico estas iniciativas empresariales se llaman spin off y están promovidas por académicos (investigadores, docentes, estudiantes) que deciden iniciar el camino emprendedor para que una tecnología que han desarrollado esté disponible para resolver problemas puntuales. Basan su actividad en la producción y comercialización de nuevos procesos, productos o servicios que parten del conocimiento adquirido o los resultados obtenidos en la propia universidad.
“En la UNL se promueve este tipo de iniciativas con diversas acciones porque tienen un alto impacto social como ser la generación de empleo altamente calificado, la promoción de nuevos desarrollos tecnológicos y la capacidad de generar alto valor agregado en la actividad económica y nuevas posibilidades de exportaciones, aportando al desarrollo regional ”, describió Javier Lotterberger, secretario de Vinculación y Transferencia Tecnológica de la UNL, la dependencia de la Universidad que diseña e políticas implementadas para apoyar este tipo de proyectos.
En esta oportunidad, se presentan dos empresas vinculadas a la biotecnología: Infira SA y Biosynáptica SA, surgidas de laboratorios con pertenencia a la UNL y al Conicet, y cuyo desarrollo tecnológico apunta a dar respuesta a necesidades sociales muy actuales.

Infira: Plantas Mas resilientes, Productivas y perennes
Jóvenes Científicas Dependientes de la UNL y el Conicet Han Desarrollado Una Tecnología Que permite dar Una respuesta a uno de los Desafíos Mas Grandes Que enfrentamos Los Seres Humanos en el siglo XXI: un Generar un nuevo modelo agrícola pecado necesidad de transformar el territorio y respetando el medio ambiente.
Para ello proponen una innovación biotecnológica para la mejora de variedades vegetales de valor productivo. Renata Reinheimer, doctora, investigadora independiente del Conicet y profesora asociada de la UNL y Carolina Bellino, licenciada en Biotecnología y becaria doctoral arribaron a estos resultados a partir de investigaciones llevadas a cabo en un equipo de investigación, del Laboratorio de Evolución del Desarrollo (LED ) del Instituto de Agrobiotecnología del Litoral , dependiente de la UNL y el Conicet.
Este equipo investiga los mecanismos genéticos que han originado características morfológicas, fisiológicas y bioquímicas novedosas en plantas en el curso de la evolución. “Descubrimos el método por medio del cual podemos extender la vida de las plantas, las que al mismo tiempo se vuelven más productivas y resilientes, es decir, resistentes al estrés. En otras palabras logramos transformar a las plantas en potencialmente inmortales”, dijo Reinheimer y agregó“ a partir de esta tecnología se pueden desarrollar plantas modificadas que muestran un incremento en el ciclo de vida, una producción de biomasa significativamente mayor con un sistema radicular sumamente vigoroso y además resistentes al estrés. Lo bueno de este método es que se puede usar en diferentes vegetales de interés productivo”.
Este método de mejoramiento vegetal ha sido protegido a partir de la presentación de una patente argentina y una solitud internacional. Para continuar con el desarrollo de esta tecnología y su posterior comercialización se firmó un convenio de licencia entre la UNL, el Conicet y la empresa Infira SA. Esta empresa está conformada por Renata Reinheimer, Cecilia Arolfo y María Victora Nagel.
Además, Infira recibió inversión inicial de la Aceleradora Litoral, quien la está acompañando en la consecución de hitos tecnológicos y de negocios a partir de un plan de aceleración específicamente diseñado para la búsqueda de inversiones. Es la primera firma de la ciudad de Santa Fe en ingresar a al portfolio de esta Aceleradora. Sobre el proceso de transferencia, Reinheimer destacó “representa un hito significativo para nuestro grupo de trabajo, el laboratorio y las instituciones participantes, y es una forma de valorizar el conocimiento científico que hemos alcanzado. El haber logrado este objetivo es clave ya que abre el camino para acercar los resultados del laboratorio al medio socio productivo”.
Biosynáptica: fármacos para enfermedades neurodegenerativas
Esta empresa se propone el desarrollo de fármacos innovadores destinados al tratamiento de enfermedades neurodegenerativas, aportando respuestas a patologías para las cuales existen tratamientos ineficaces.
“Las neurodegenerativas son trastornos que se caracterizan por un deterioro progresivo de la función motora o cognitiva provocado por una pérdida selectiva de neuronas dentro del sistema nervioso central. Entre las enfermedades más conocidas se encuentran el Alzheimer, el Parkinson o la esclerosis lateral amiotrófica (ELA), que provocan serias consecuencias cognitivas, físicas y psicosociales. Estas características, junto con la ausencia de tratamientos efectivos, generan que desde la ciencia a nivel mundial, se esté trabajando denodadamente para desarrollar medicamentos que provean beneficios clínicamente sustentables ”, señaló Marcos Oggero Eberhardt, investigador de la UNL y el Conicet, integrante del equipo de trabajo.
Teniendo en cuenta esta problemática, en el Centro Biotecnológico del Litoral de la Facultad de Bioquímica y Ciencias Biológicas de la UNL , investigadores que también tienen pertenencia al Conicet lograron modificar una molécula humana que aumenta su acción neuroprotectora y neuroplástica. Mediante modelos computacionales demostraron que estas moléculas pueden mejorar las consecuencias cognitivas, físicas y psicosociales que estas patologías provocan.
"Nuestro desarrollo busca sustituir fármacos orientados a esas patologías, muchos de los cuales solo muestran acción sintomática, que se orienten hacia la recuperación del paciente mediante tratamientos que lo protejan del avance de la enfermedad y establezcan las bases para mejorar su calidad de vida", añadió Oggero Eberhardt. El equipo está conformado por los doctores Matías Depetris; María de los Milagros Bürgi, Ricardo Kratje y Marcos Oggero Eberhardt.
Los trabajos de investigación iniciaron en 2013 y durante el proceso contaron con la cooperación del Laboratorio de Neurobiología Molecular y Celular del Instituto de Investigaciones Biotecnológicas de la Universidad Nacional de San Martín y el Conicet, dirigido por la Dra. Camila Scorticati y con la participación de la Lic. Gabriela Aparicio.
La tecnología ha sido protegida a partir de la presentación de solicitudes de patentes tanto en Argentina como en más de 20 países de Asia, Europa y América con el fin de resguardar la propiedad intelectual de la innovación y poder atraer capitales que quieran invertir en el desarrollo. También el grupo ha sido asesorado para la búsqueda de fondos públicos y privados para financiar el trabajo. También se ha firmado un convenio de incubación de la empresa, en el marco de la UNL, para que el grupo pueda avanzar en el desarrollo de la tecnología y su puesta a punto para ser incorporada al mercado, mediante su licenciamiento a otras empresas biofarmacéuticas.
De cómo nace y crece un spin off universitario
Conseguir trasladar conocimiento que se produce diariamente en las Universidades no es un camino fácil, lograr que la investigación pueda concretarse en aplicaciones prácticas tampoco. Una de las alternativas se presenta con la creación de un spin off universitario, en el cual los investigadores ponen en marcha una empresa, que luego podrán hacer crecer o vender.
Un spin off tiene ventajas para todos los implicados, ya que los emprendedores pueden continuar con desarrollando la tecnología que crearon con sus actividades de investigación; contratar o asociarse con otros profesionales y emprendedores que sumarán talento; obtener un rendimiento económico del proceso; y continuar con sus tareas de docencia e investigación que se verán más enriquecidas con el conocimiento de la práctica.
Por su parte, la Universidad puede impulsar proyectos de transferencia de los resultados de la investigación y ampliar el conocimiento que se genera.
En términos más generales, la sociedad principalmente se beneficia con la resolución a alguna problemática particular, en estos nuevos casos, son potencialmente plantas perennes y nuevos medicamentos.
Se suma además el hecho de que estas empresas crean nuevos puestos de trabajo cualificados, y mayor crecimiento económico a partir de la producción de alto valor agregado.
Para llegar a esta etapa se necesitan herramientas de apoyo por parte del propio sistema universitario, del estado y de otros actores del sistema de innovación. En el caso de la UNL, la casa de estudios cuenta con instrumentos e infraestructura que promueven la investigación y la incubación de empresas; y personal capacitado para el asesoramiento en propiedad intelectual, búsqueda de fondos e inversiones y gestión de negocios tecnológicos. Por ejemplo, en el caso puntual de estos dos proyectos “ambos fueron parte de convocatorias de Capital Semilla, que obtuvieron financiamiento de la Universidad y se trabajó en la redacción de las patentes nacionales y solicitudes internacionales. Además, recibieron asesoramiento para presentar y gestionar fondos de organismos públicos. Estas son acciones del Programa de Valorización de conocimientos que lleva adelante nuestra oficina, en el cual se busca acercar los desarrollos tecnológicos al sector productivo. ” comentó Christián Nemichenitzer, director del Cetri Litoral.
Asimismo, reciben el acompañamiento del Programa de Generación, Incubación y Desarrollo de Empresas de la UNL. La generación de spin off universitarios unen dos factores relacionados al crecimiento económico de un país: la actividad emprendedora y el conocimiento como fuente de ventaja competitiva, y mostrar una comunidad universitaria proactiva, dispuesta a promover cambios en su entorno, a partir de innovaciones surgidas en laboratorios, institutos y aulas.
Para mayor información sobre el tema ingresar en www.unl.edu.ar/vinculacion









